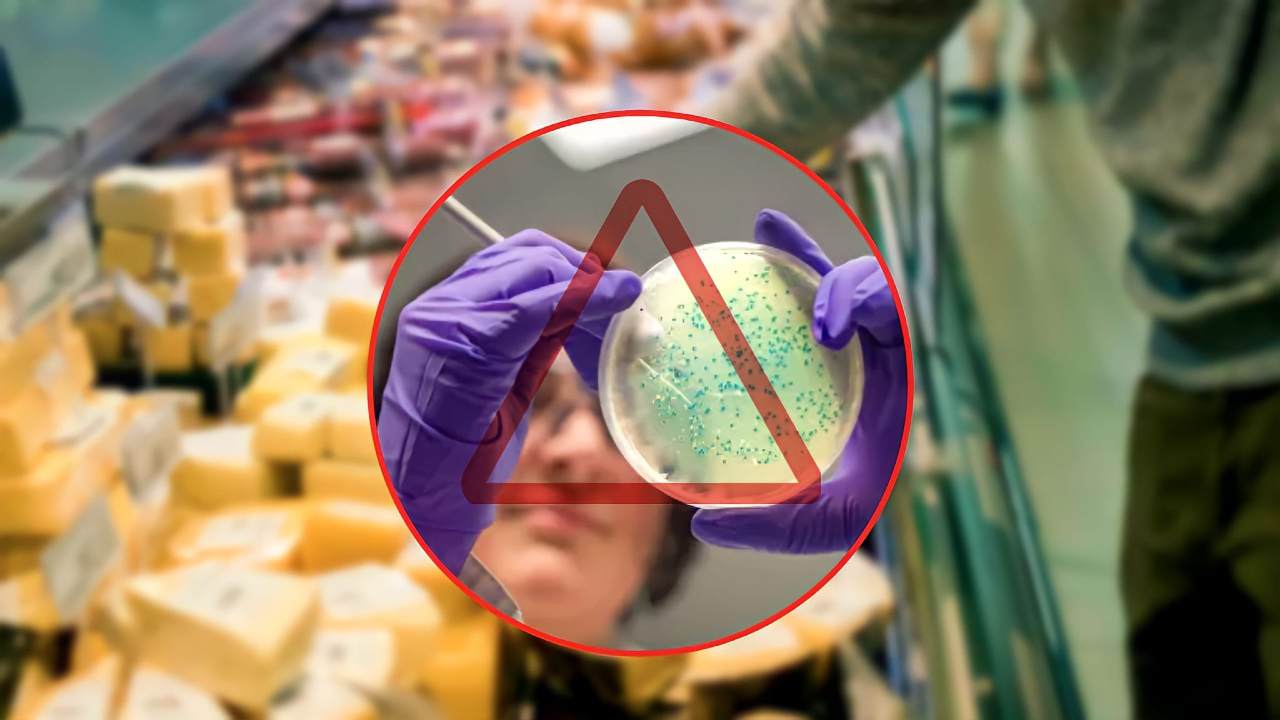

Un noto marchio di formaggio è stato ritirato dal commercio per via della presenza di listeria. Ecco il comunicato del Ministero della Salute.
Sulle tavole di tutti noi, spesso compaiono molti cibi che hanno una predisposizione ad essere affetti da determinati batteri e quindi bisogna stare molto attenti alla loro conservazione.
Ma molte volte, questi sono presenti sin dal loro acquisto e di conseguenza non possiamo accorgercene se sono presenti dei batteri che potrebbero dare dei problemi per la nostra salute come il Listeria Monocytogenes .
Sintomi del Listeria Monocytogenes
Tra i cibi che più possono essere colpiti da listeria oltre i formaggi molli ci sono il salmone affumicato, i paté, i cibi poco cotti, i salumi la cui stagionatura è minima, la carne cruda e in particolare la frutta e la verdura, specie se non lavata e sciacquata adeguatamente.
La sintomatologia della listeria si presenta come forme simili all’influenza e a alle intossicazioni alimentari con comparsa di febbre e brividi, dolori muscolari e articolari, diarrea, nausea e vomito.
I sintomi possono essere lievi oppure forti e spesso viene scambiato per l’appunto come una forma influenzale e non si accorge invece di essere stati affetti dalla listeria. Per questo motivo l’Istituto Superiore di Sanità ha dato alcuni consigli prima di mangiare i cibi per evitare un contagio di listeria.
Tra i consigli c’è quello di lavare spesso le mani e tutte le superfici della cucina e tutti gli utensili che entrano a contatto con gli alimenti e anche di conservare gli alimenti che possono essere affetti da questo virus in contenitori separati dagli altri cibi, in frigo.
Inoltre, tra i consigli c’è quello di cuocere i cibi ad alta temperatura seguendo i consigli riportati in etichetta, dato che con le alte temperature il batterio tende a sensibilizzarsi e quindi a perdere la sua efficacia.

Nei giorni scorsi, anche il prosciutto cotto del marchio Sapor di Cascina venduto dalla catena di supermercati Penny Market è stato ritirato dal commercio per la presenza di listeria nella sua confezione da 150 grammi.
Di conseguenza è sempre meglio consultare di tanto in tanto il sito del Ministero della Salute o le pagine social dei supermercati dove siamo abituati a fare la spesa per accertarsi che il prodotto acquistato non presenti batteri nocivi nel nostro organismo.
Qualora si è in possesso di un prodotto che ha subito un richiamo, questo va portato presso il supermercato dove ci daranno un rimborso totale del prezzo dell’articolo.
Formaggio: richiamato un noto marchio per presenza di listeria
Per questo motivo, il Ministero della Salute, dopo alcune segnalazioni e controlli richiama determinati prodotti e invita i consumatori a non alimentarsi con quel determinato cibo riportando indietro il prodotto per farsi riavere un rimborso.
Negli ultimi tempi, sono stati tanti i prodotti messi in commercio ad essere stati ritirati tra cui una linea di bicchieri che poteva contenere dei pezzi pericolosi per la salute se ingeriti e dei lotti di gelato per la presenza di sostanze nocive.
Adesso, ad essere colpito è un formaggio molto famoso e molto venduto che sulle tavole degli italiani non manca e con il quale ci si può sbizzarrire in molte ricette per stupire i nostri ospiti o per golosità e soddisfare il nostro palato.
Stiamo parlando del Gorgonzola, nella fattispecie quello sottoposto a richiamo è stato il Gorgonzola Dolce DOP della linea Pascoli Italiani messo in commercio dalla catena di supermercati EuroSpin Italia.
Come si può leggere dal comunicato pubblicato sul sito del Ministero della Salute, il lotto ritirato dal commercio è il numero 218246252 che presenta come marchio di identificazione il codice It 03 39 CE con scadenza l’8 novembre 2022 del prodotto dal peso di 300 gr.
Il Ministero della Salute ci comunica che all’interno di questo prodotto potrebbe esserci la presenza del batterio Listeria Monocytogenes che provocherebbe problemi di vario tipo come sopra elencato. Nel caso aveste in frigo questo prodotto, come anticipato, riportare immediatamente la confezione al supermercato e non consumarlo per sicurezza.







